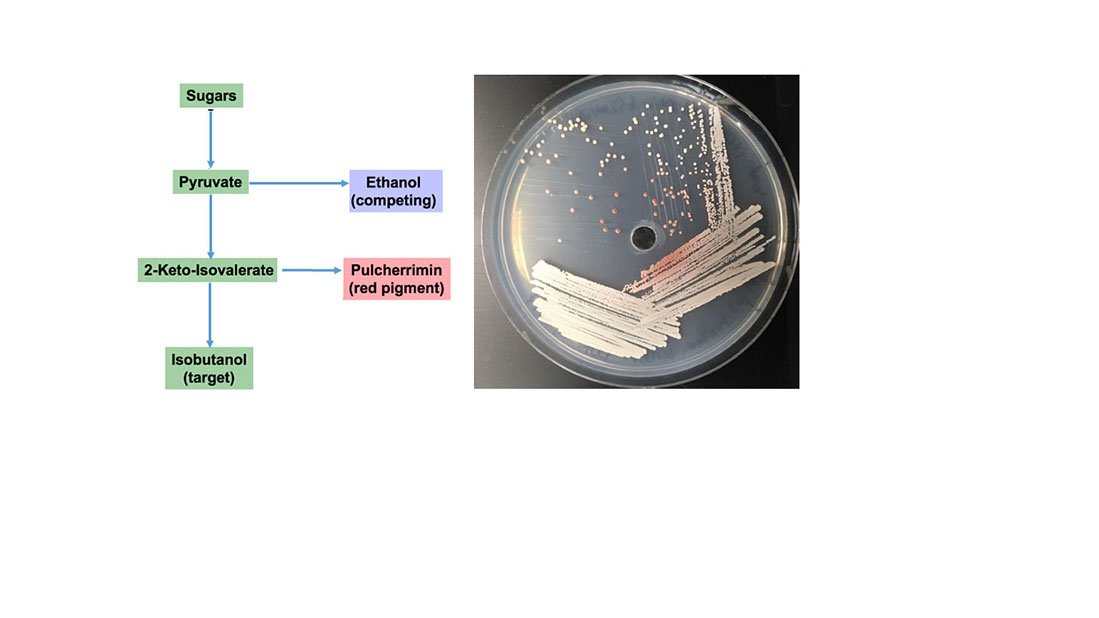

Landmark Photosynthesis Gene Discovery Boosts Plant Growth, Advances Crop Science
A novel gene, BOOSTER, enhances plants’ photosynthesis efficiency and productivity.

A novel gene, BOOSTER, enhances plants’ photosynthesis efficiency and productivity.

Genetically modified bacteria brews two valuable products from underutilized plant fiber, potentially reducing fossil fuel use.

Pseudomonas putida uses cheap plant biomass as a carbon source to make the precursor isoprenol.

Breakthrough will accelerate efforts to tap the potential of this important perennial grass, a promising crop for sustainable bioenergy production.

New improvements to an open-source platform streamline enzyme engineering.

Varieties of switchgrass with different numbers of genome copies use different strategies in adapting to changes in climate and location.

Elucidating the plant’s ability to tweak its defense response to specific pathogens.

Adding glucose to a green microalga culture induces accumulation of fatty acids and other valuable bioproducts.
Read more about Feeding Sugars to Algae Makes Them Fat
Identified genes involved in plant cell wall polysaccharide production and restructuring could aid in engineering bioenergy crops.
How yeast partition carbon into a metabolite may offer insights into boosting production for biofuels.

Researchers discover how certain bacteria may safeguard plant growth during a drought, making way for strategies to improve crop productivity.

Evidence suggests that biorefineries can accept various feedstocks without negatively impacting the amount of ethanol produced per acre.